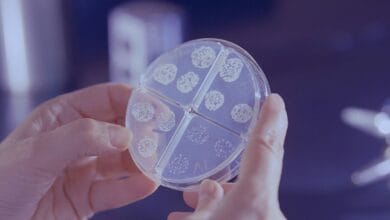
Can Bacteria Cause Breast Cancer? New Research Insights

Breast Cancer Studies
- Health & Medicine

Can Bacteria Cause Breast Cancer? What New Research Reveals
From ancient times, bacteria have supported human life in many ways. Early communities used them to prepare foods like curd,…
Read More »
From ancient times, bacteria have supported human life in many ways. Early communities used them to prepare foods like curd,…
Read More »